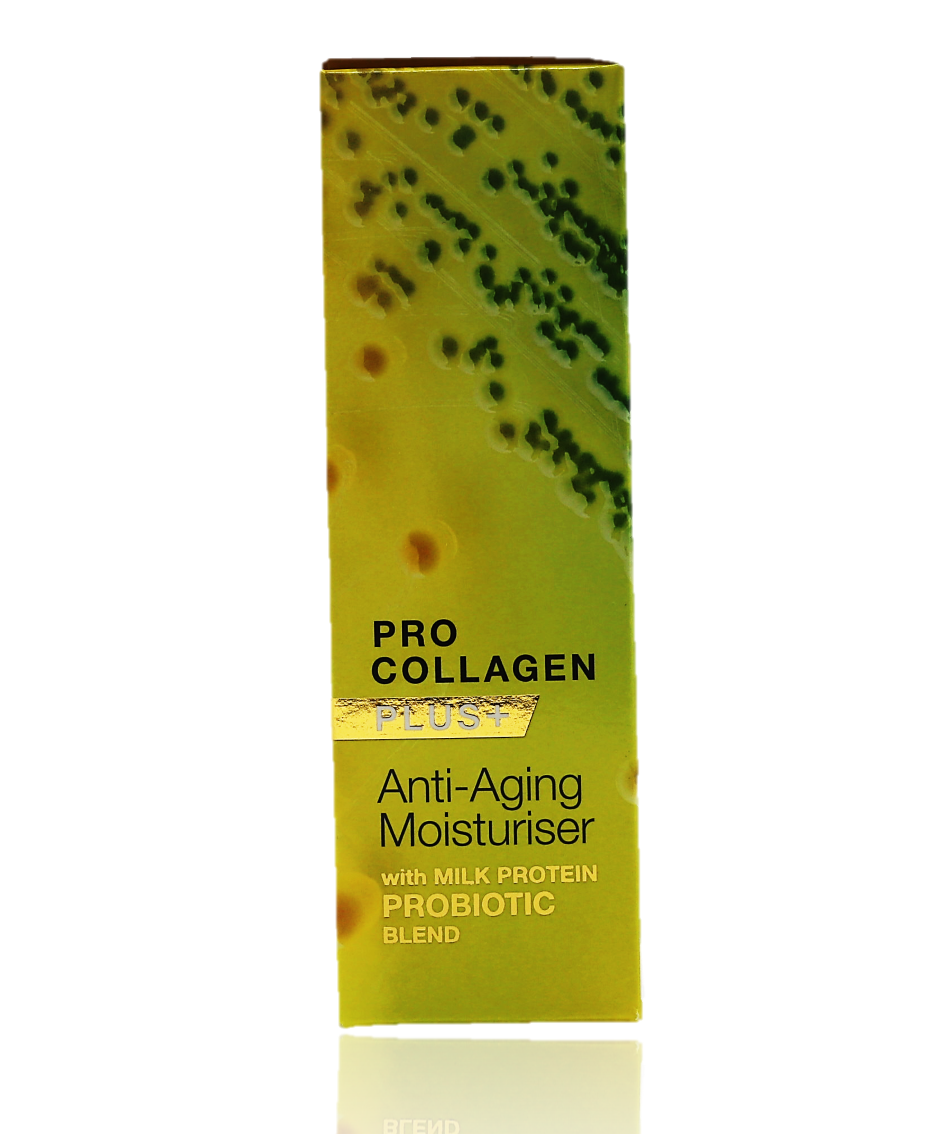
Dr Organic Anti-Aging Moisturiser with Milk Protein 50ml - Healthy Essentials Australia - health food store - health food stores - health food store near me - organic food store - health food store near me

- With Probiotic Milk Protein & Blackberry Leaf Extract
- Pro Collagen Plus+
- For Firmer, Smoother Skin with Anti-wrinkle Formula
- 95% Clinically Proven
- Vegetarian Friendly
Dr Organic Anti-Aging Moisturiser with Milk Protein 50ml
ADD SOMETHING EXTRA
WHAT THEY'RE SAYING ABOUT US
- With Probiotic Milk Protein & Blackberry Leaf Extract
- Pro Collagen Plus+
- For Firmer, Smoother Skin with Anti-wrinkle Formula
- 95% Clinically Proven
- Vegetarian Friendly
Healthy Essentials Australia ships nationwide using couriers and other freight carriers. Orders will be charged a flat shipping fee of $14.95, or your can choose Express Shipping for $17.95. Please note that when choosing Express Shipping your order will be shipped within 24hours (business hours). You will see the relevant charge before your payment is required at checkout. Please be aware that shipping is calculated on cost after any discounts or coupons are applied. We also offer same day shipping within Metro Melbourne area at $19.95 when orders are placed before 12 noon.
All delivery times are indicative only and delays may occur during transit. We do not guarantee delivery times however provide estimates only based on our freight provider. Due the the current climate, delays are expected and we apologise for any inconvenience this may provide.
Returns
If you receive the incorrect product in your order, please email us at [email protected] or phone. If the product is unopened and intact, we ask that the product be returned and will arrange for your order to be resent at no additional charge. If you have received a product that has exceeded its use by date when received or if faulty, Healthy Essentials Australia will replace the product at no additional cost.Next day Delivery
Ethical & Sustainable
Australian Made
Health & Wellbeing